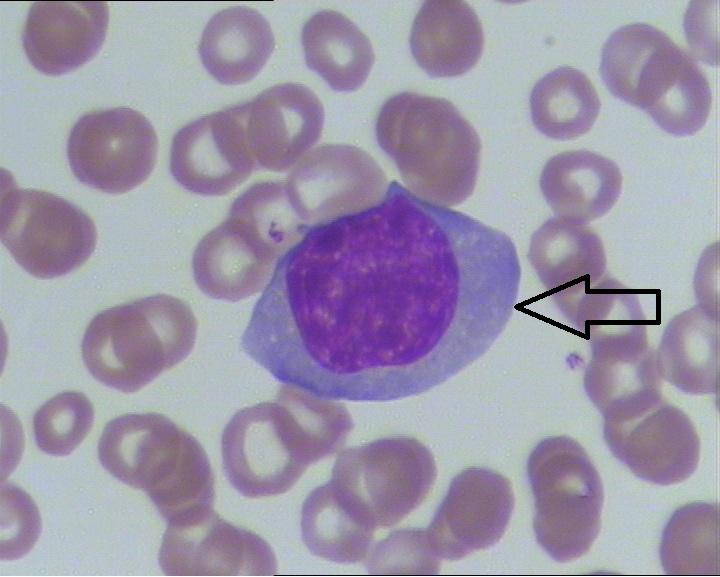

【第一百二十七期】基层检验网形态学培训
【第一百二十七期】基层检验网形态学培训
每周一次,每次几张,只要您坚持来,抽出几分钟的时间,相信您的识图能力会不知不觉的提升哦
1、请指出下图箭头所指细胞名称(骨髓标本 瑞氏染色 10×100 )。

答案:骨髓瘤细胞/火焰浆细胞
解析:胞体大,直径约 30-50μm,细胞外形不规则,可有伪足。胞核圆形,偏心,核染色质疏松,排列较紊乱,部分可见 1-2 个大而清楚的核仁。胞浆量丰富,呈灰蓝色或呈火焰状不透明,常含有少量嗜苯胺蓝(嗜天青)颗粒或空泡。有些瘤细胞含嗜酸性包涵体(Russell小体)或大量空泡(桑椹细胞)或排列似葡萄状的浅蓝色空泡(葡萄状细胞)。也可见双核,多核,多个分叶,多型性瘤细胞。
2、请指出下图箭头所指细胞名称(骨髓标本 瑞氏染色 10×100 )。

答案:原始红细胞
解析:胞体直径约 15~20μm,圆形或椭圆形,边缘常有钝角状或瘤状突起。胞核圆形、居中或稍偏于一旁,约占细胞直径的 4/5,核染色质呈颗粒状较原粒细胞粗而密集,核仁 1~3 个不等,且大小不一,形状不规则,呈浅蓝色或暗蓝色;胞浆量少,染深蓝色、不透明,在核周围常形成淡染区,有油画蓝感,无颗粒
3、请指出下图箭头所指细胞名称(骨髓标本 瑞氏染色 10×100 )

答案:幼稚单核细胞
解析:其胞体直径 15~25μm,圆形或不规则,有时可有伪足。胞核常不规则,呈扭曲、折叠状,或有凹陷或切迹,核染色质开始聚集成丝网状,核仁有或消失。胞质较丰富,呈灰蓝色、不透明,部分可见细小紫红色的嗜天青颗粒和空泡。
4、请指出下图箭头所指细胞名称(外周血标本 瑞氏染色 10×100 )
答案:反应性淋巴细胞/异型淋巴细胞
解析:胞体偏大,10-30μm,胞体形态多样,有时受周围细胞挤压呈裙边样,胞质变多、胞质深蓝色,有的含有空泡、颗粒,胞核也较大,核规则或不规则,染色质变得疏松,有的甚至隐约可见核仁。Downey 将异型淋巴细胞分为三型:Ⅰ型(空泡型、浆细胞型)、Ⅱ型(不规则型、单核细胞型)、Ⅲ型(幼稚型、幼稚淋巴细胞型)。
5、请指出下图箭头所指细胞名称(骨髓标本 瑞氏染色 10×100 )。

答案:异常早幼粒细胞/柴捆细胞
解析:细胞大小不一,外形不规则,常有瘤状突起;胞核略小,常偏位,形态多样,可呈凹陷、折叠、扭曲、双核或分叶状,核染色结构不定,核仁 1-3 个,有的被颗粒遮盖而不清楚;胞质丰富,呈蓝色或灰色,充满大量粗大的紫红色嗜天青颗粒,致使核、质分界不清,但也有细胞颗粒纤细,较少,类似单核细胞。Auer 小体易见,若多条 Auer 小体呈束状交叉排列,形似柴捆样,称之为“柴捆细胞”。
感谢:重医大附一院检验科和重庆市黔江质控中心提供的内容。


